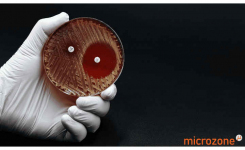
Petri dish showing antibiotic resistance

Why Choose Microzone’s Free From Range?
Microzone’s Free From range offers a streamlined workflow that is both faster and more sustainable, reducing the need for excessive plastic and chemicals. Here’s why this innovative solution is becoming a top choice for infectious disease researchers:
Speed and Simplicity
Rapid Sample Preparation: Our workflow reduces the time from sample collection to result, essential for the timely detection and intervention of infectious outbreaks.
Direct-to-PCR Capability: Unlike traditional methods that require extensive purification steps, our MicroLYSIS Plus buffers enable direct DNA/RNA extraction from a variety of samples with minimal handling.
Sustainability
Reduced Plastic Waste: By eliminating the need for columns, magnetic beads, and multiple pipetting steps, our Free From range significantly lowers the use of consumables, contributing to a more sustainable lab environment.Lower Chemical Use: Our processes avoid the use of solvents and alcohols, ensuring a safer, more eco-friendly workflow.
Efficiency and Reliability
High Yields and Purity: Achieve exceptional yields and purity of DNA/RNA suitable for downstream applications such as qPCR, PCR, and sequencing.Consistent Results: Our products, like the MegaMix PCR mastermixes, ensure stability and consistency, crucial for reliable and reproducible results.
Key features of Microzone’s Free From workflow include....
✓Single-tube simplicity
✓Rapid sample preparation
✓Reduced plastic waste
✓Low chemical use
✓Time-efficient and reliable
✓Eco-friendly
If you would like to know more, download our poster here.